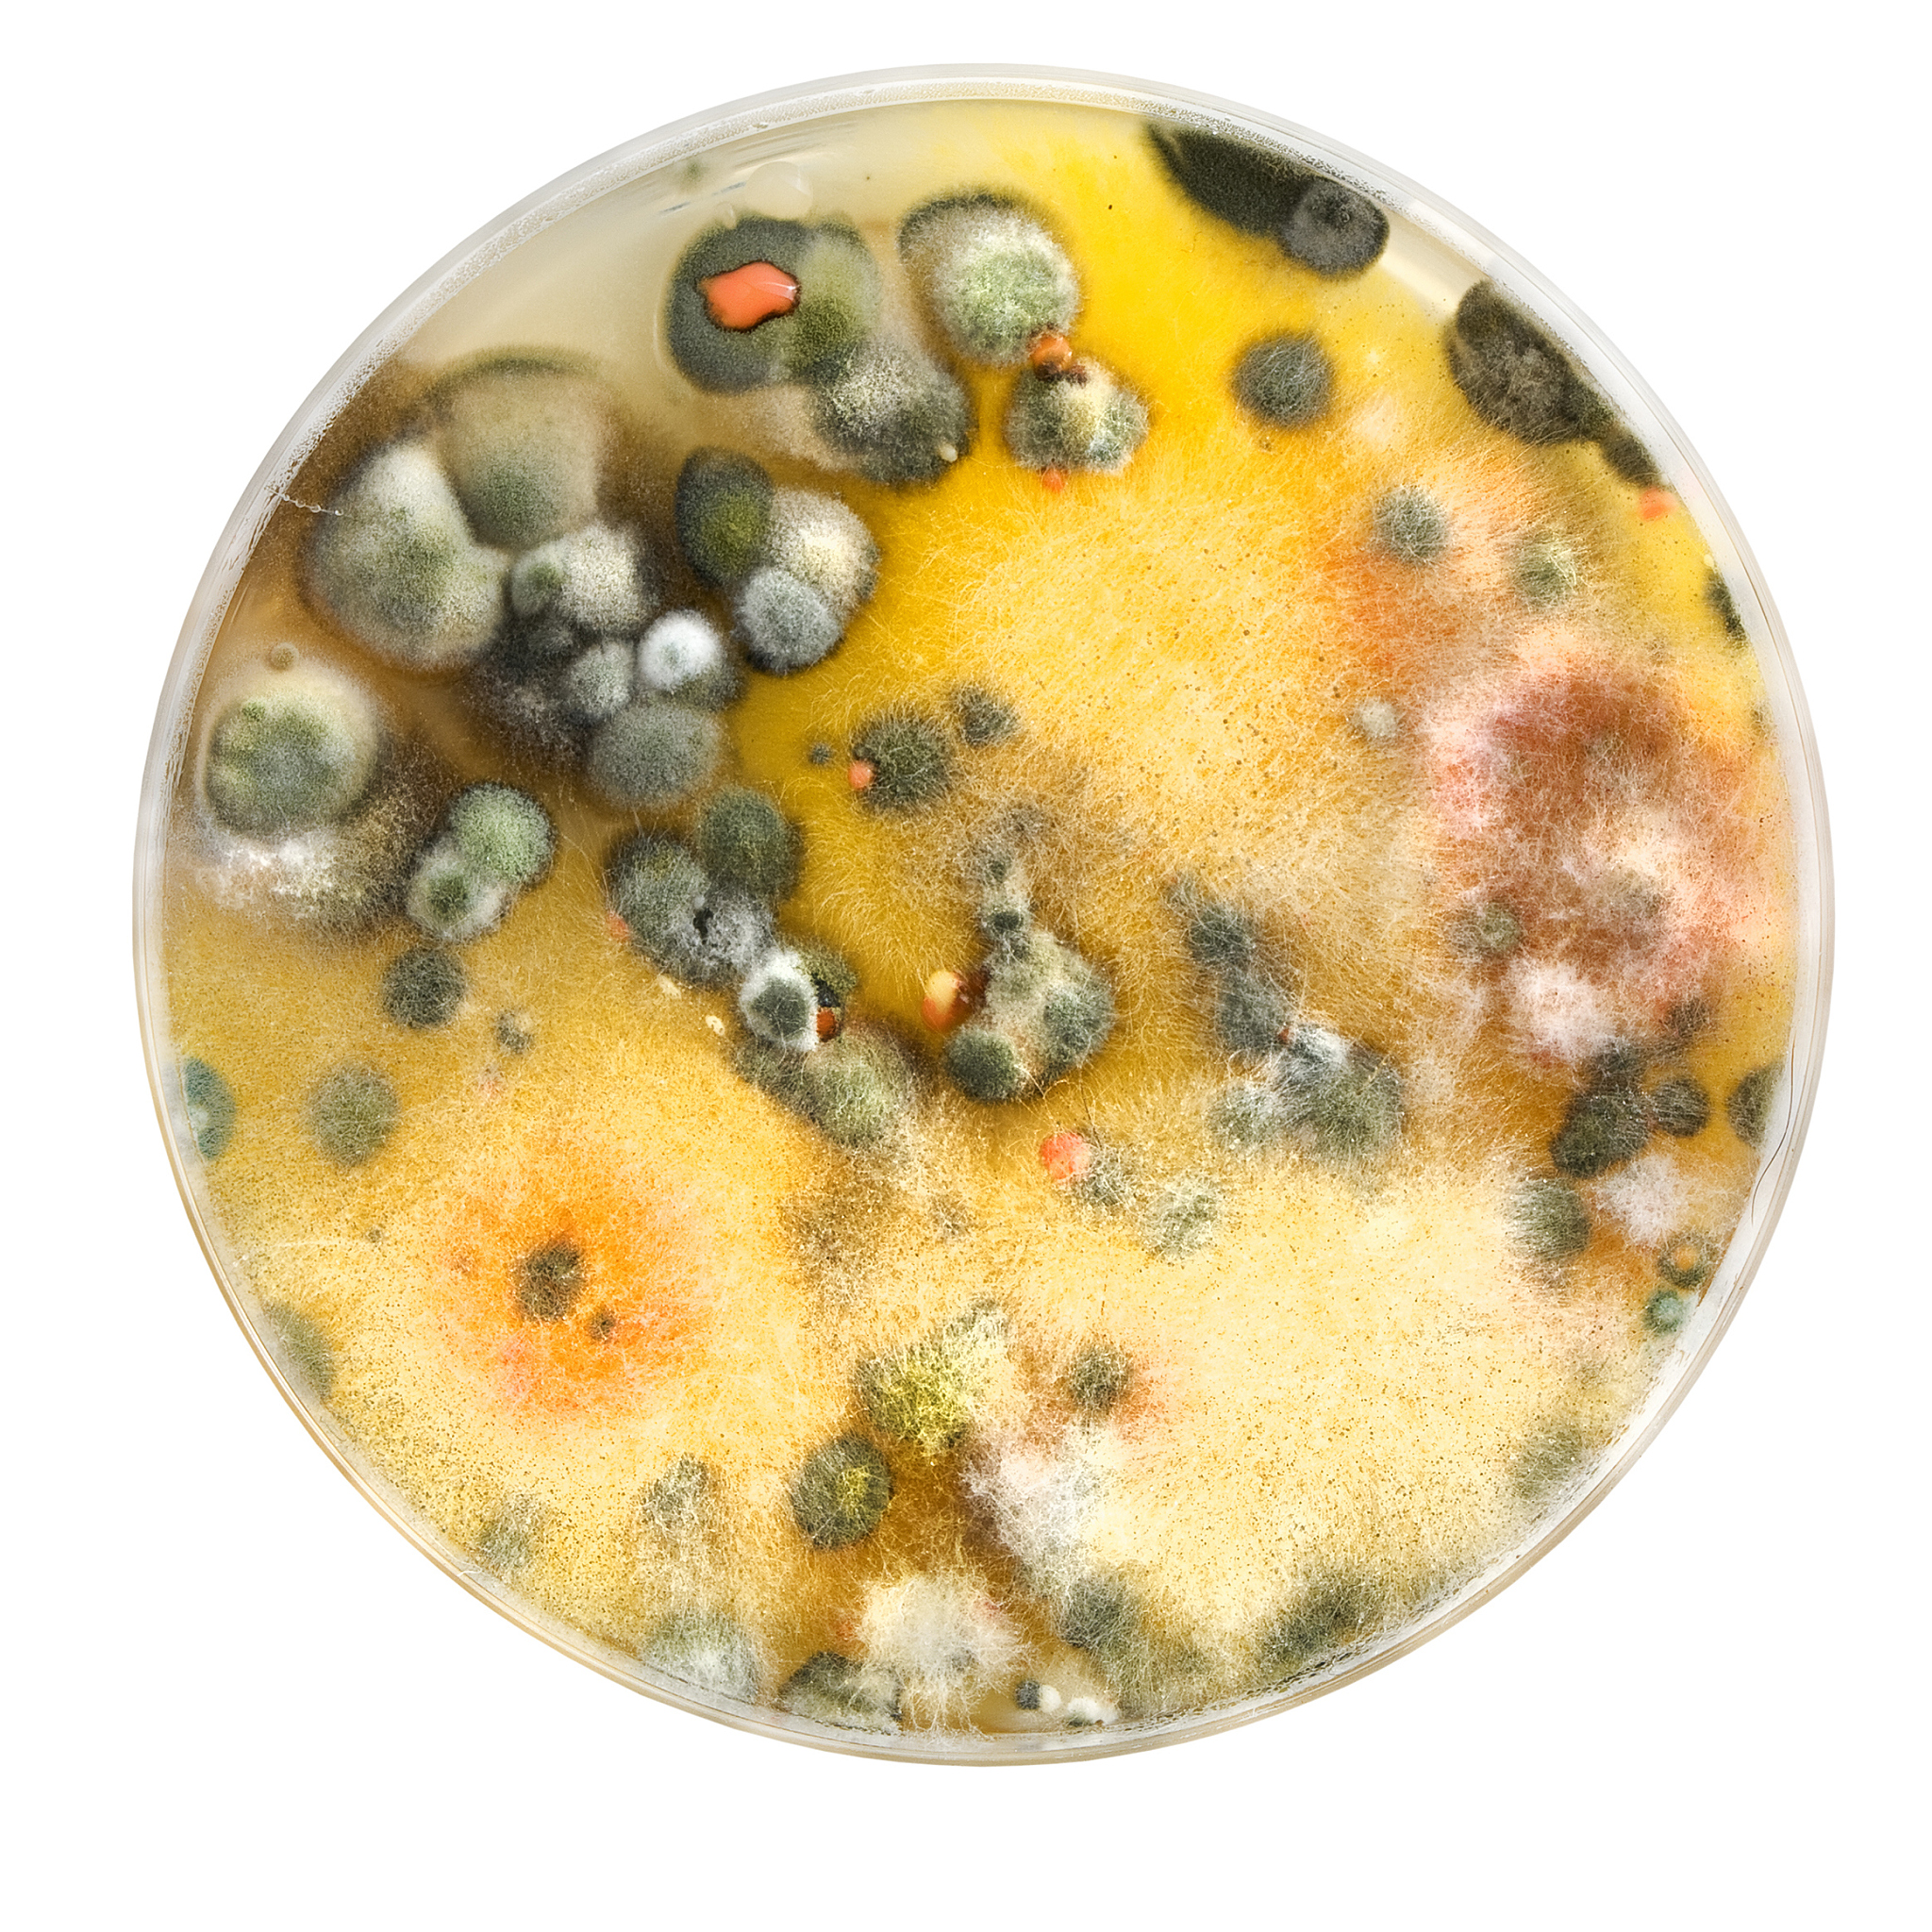
Fungal Biology期刊研究范围详细介绍

Fungal Biology期刊研究范围详细介绍
《Fungal Biology》是一本国际性的学术期刊,涵盖了真菌生物学的各个方面。该期刊的主要研究范围包括但不限于以下内容:
-
真菌分类学与系统学:研究真菌的分类、命名、进化关系以及系统发育。
-
真菌生理学与生化学:探索真菌的生长、发育、代谢和适应性机制,包括营养摄取、分解和合成、信号传导等方面的研究。
-
真菌遗传学与基因组学:研究真菌的遗传变异、基因组结构和功能,包括基因调控、表达调控、遗传标记和基因组测序等方面的研究。
-
真菌生态学与环境学:研究真菌在自然环境中的生态角色、功能和相互作用,包括真菌与其他生物的共生关系、环境适应性和生态系统功能等方面的研究。
-
真菌病理学与病害防治:研究真菌引起的病害,包括病原菌的鉴定、致病机制、病害防治策略等方面的研究。
-
真菌生物技术与应用:研究真菌在工业、农业、医药等领域的应用,包括发酵工艺、生物转化、药物开发等方面的研究。
总之,《Fungal Biology》致力于推动真菌生物学领域的研究和交流,为科学界提供一个广泛的平台,促进真菌生物学的发展和应用。
原文地址: http://www.cveoy.top/t/topic/iIv1 著作权归作者所有。请勿转载和采集!